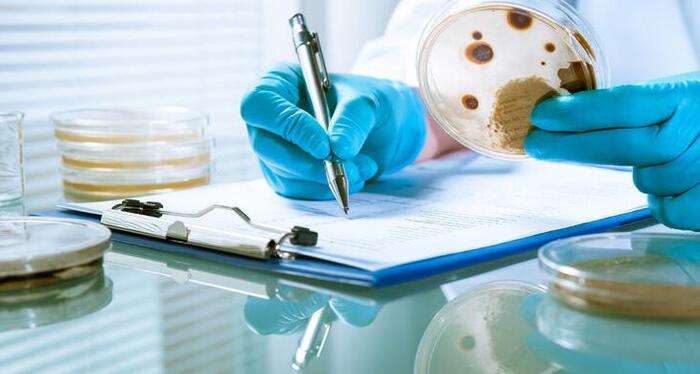
头孢照片实物【头孢照片 真实图片】

感冒了怎么办?乱用阿莫西林和头孢,可能会“养”出超级细菌!
据央视报道,福建11岁的小金(化名)流鼻涕、鼻塞很久了,家人一直以为是感冒,每次发作的时候,就给小金吃“消炎药”阿莫西林和头孢。没想到吃了很久,效果却很差,病情总是反反复复,把小金折磨得够呛,家长只好把他带到医院检查。
医生取了一点小金的鼻腔分泌物去做检查,检查结果让医生吓了一跳。竟然发现了一种叫做“MASA”的超级细菌,包括阿莫西林和头孢在内很多抗生素都无法杀灭。在一个年仅11岁的孩子身上发现超级细菌,这种情况是非常罕见的,而超级细菌的出现和小金长期滥用抗生素有着莫大的关系。
一、阿莫西林和头孢,不是感冒药别乱用阿莫西林和头孢都是抗生素类药物,这类药物的作用是抵抗细菌,而感冒多是由病毒引起。用抗病菌的药物来抗病毒,自然起不到效果,还可能会增加抗药性和产生毒副作用。
抗生素类药物是个“大家族”,包括有青霉素类、头孢类、红霉素类、四环素类、喹诺酮类以及磺胺类等,这些药物都是抗菌药。其中,阿莫西林属于青霉素类的具体一种药物,而头孢则是抗生素中一大类药物的总称。
这时候有人会说了,既然两种药都不是感冒药,但是它们都同为抗生素类药物,岂不是可以通用?
二、即使同为抗生素也不能乱用,阿莫西林和头孢有区别头孢和阿莫西林虽然都是抗生素,但是所针对的病症却不同,头孢的作用机理是抑制细胞繁殖和分裂,破坏细胞壁来达到治疗效果,对于一些外伤、红肿热痛引起的炎症可起到缓解效果;而阿莫西林则具有很强的杀菌能力,进入体内后可穿透细胞壁,对于敏感菌所致的炎症具有很好的治疗效果。
北京安贞医院药事部主任药师林阳表示,阿莫西林虽然具有很好的抗菌效果,却也不能滥用。目前临床上主要将阿莫西林用于中耳炎、鼻窦炎等呼吸道感染,尿道炎、细菌性阴道炎等泌尿生殖道感染,皮肤感染如皮肤组织化脓,肺炎、支气管炎等下呼吸道感染,幽门螺杆菌感染,还有急性单纯性淋病等病的治疗,它对于病毒性肺炎、霉菌性阴道炎、过敏性鼻炎等病是无效的。
不少人在生活中一有个头疼脑热就不分青红皂白地服用抗生素,殊不知这么做很可能会给健康带来一些难以承受的后果。
三、滥用抗生素,这些后果很难承受人体内有超8成的免疫功能需构建在肠道内的益生菌平衡上,这些菌种在免疫系统功能中发挥极为重要的作用。长期滥用抗生素会导致肠道菌群失衡,大量益生菌被破坏,甚至会对免疫系统起到摧毁性的作用,当身体遭遇病菌、病毒等入侵时,身体无法及时做出反应,会变得十分容易生病。

抗生素在消灭细菌的同时,细菌也不会“坐以待毙”。为了可以生存下去,它会不断改变性质和状态,长期滥用抗生素会导致细菌产生耐药性,到最后形成无药可医的情况。浙江大学医学院第一医院传染病诊治国家重点实验室教授肖永红表示,我国每年约有8万人死于耐药性,且该数值还在不断增长中。滥用抗生素的后果,是我们所无法承受的。那么,在生活中该如何正确地使用抗生素呢?做好这三点。
四、如何合理使用抗生素?1、使用抗生素之前一定一定一定要先问医生
抗生素属于处方类药物,一定不要擅自到药店购买用药!用药前需医生结合病症、实验室数据等综合诊断后,开具处方后能购买服用。
2、不要随意加量和减量
用药时要注意定时定量,严格遵照医嘱进行。切不可随意增减药量,即便是在症状缓解之后也要坚持用药。避免出现随意停药导致病菌卷土重来,诱发更严重的感染发生。

3、部分人群慎用
抗生素并不适合所有人,如儿童应该避免使用具有肾毒性的氨基糖苷类抗菌药、8岁以下儿童要避免使用四环素类药物、18岁以下未成年人不应使用喹诺酮类药物等,肝肾功能较差的人群用药时需要严格控制用药。
任何药物在使用前都需要有专业医生的指导,不要认为药物常见就可以随意服用,这样做是对身体非常不负责任的一种表现!#健康明星计划##2021生机大会#
参考资料:
[1]《聚焦Ⅰ丨从救命到致命——抗生素的前世今生》.人民日报社民生周刊.2016.11.21
[2]《“头孢”和“阿莫西林”有什么区别?》.中国家庭报.2021.4.14
[3]《【中西药讯】“世界提高抗生素认识周”——滥用抗生素的危害你真的知道吗?》.南方医科大学中西医结合医院.2021.11.19
未经作者允许授权,禁止转载
制图网(www.makepic.net),专业的logo免费设计在线生成网站,全自动智能化logo设计,商标设计,logo在线生成!
欢迎使用制图网制作属于您公司自己的logo,不仅专业而且经济实惠,全方位满足您公司品牌化、视觉化的需求。
只需简单一步,使用微信扫码(或长按识别二维码)并在任一小程序首页根据提示获取激活码!
chatGPT中文网页版,无需注册,快来体验全网最火爆的人工智能应用!
只需简单一步,使用微信扫码(或长按识别二维码)并在任一小程序首页根据提示获取激活码!
chatGPT中文网页版,无需注册,快来体验全网最火爆的人工智能应用!